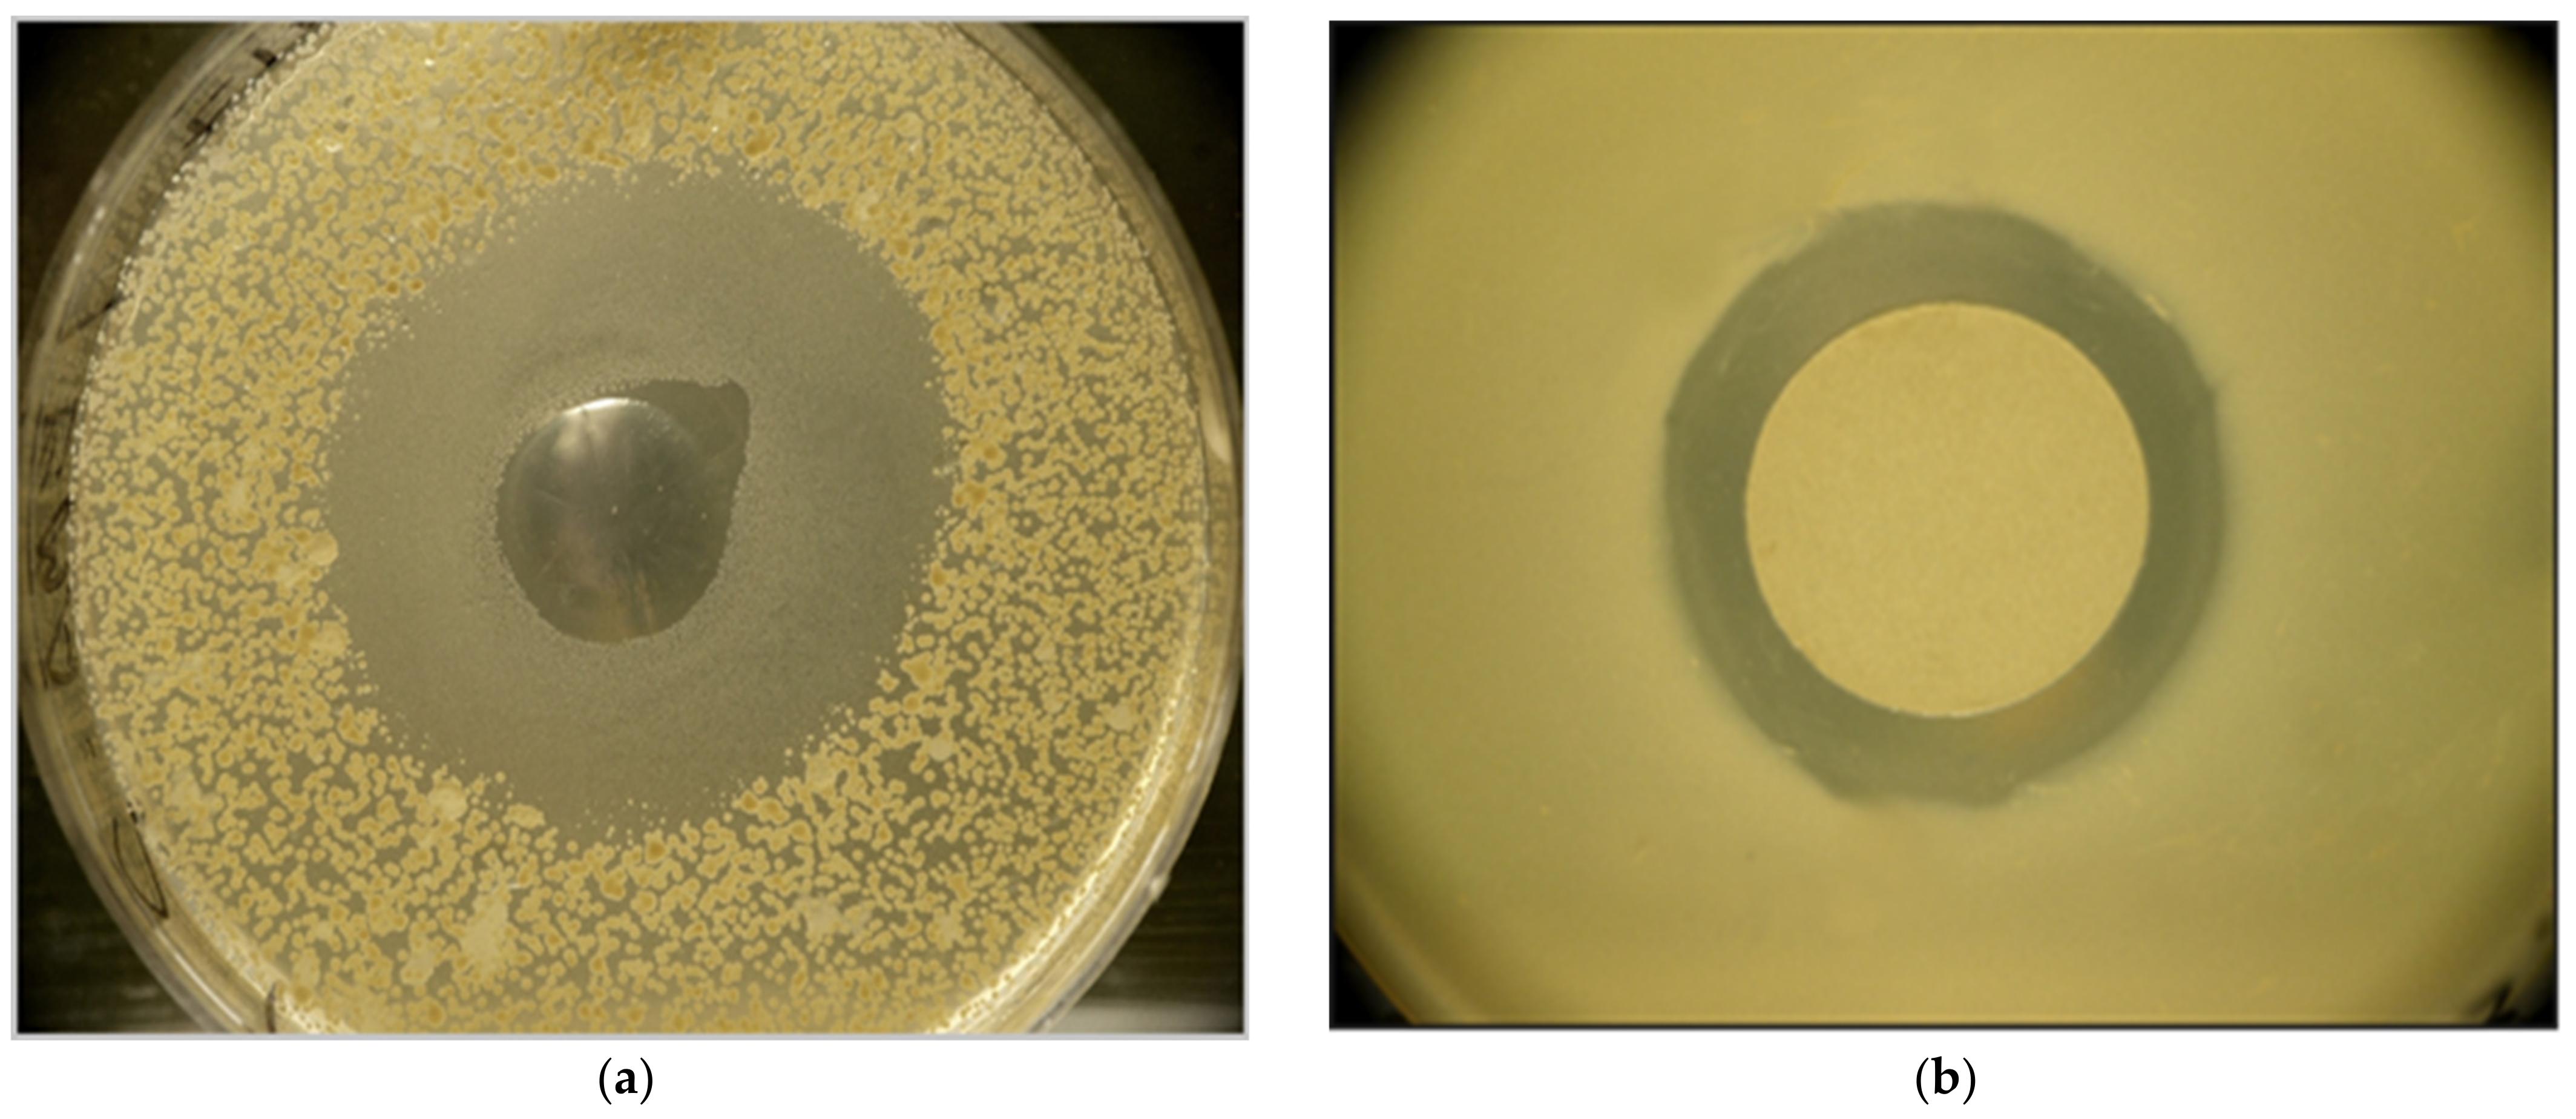
Pathogens 12 00458 g001

XENOFOOD—An Autoclaved Feed Supplement Containing Autoclavable Antimicrobial Peptides—Exerts Anticoccidial GI Activity, and Causes Bursa Enlargement, but Has No Detectable Harmful Effects in Broiler Cockerels despite In Vitro Detectable Cytotoxicity on LHM Cells
Abstract
1. Introduction
2. Results
2.1. Anti-Clostridial Activity of EMA and EMC In Vitro
2.2. In Vitro Bioassays: Cytopathogenic Effects of Cell-Free Condition Media (CFCM) of 3 EPB Species on LMH Chicken Cell Monolayer
2.2.1. Experiment-1
2.2.2. Experiment-2
2.3. Results of the In Vivo Xenofood-Feeding Experiment
2.3.1. Gastrointestinal Activity of XENOFOOD
2.3.2. Growth Rate, Feed Consumption, Feed Conversion, and the Post-Mortal Data
3. Discussion
4. Materials and Methods
5. Conclusions
- The work presented here can be considered as a contribution to the field of application of biosynthetic non-ribosomal encoded antimicrobial peptides (NR-AMPs) controlling multi-drug resistance (MDR).
- Regarding the future potential application of natural compounds, several aspects have to be taken into consideration: (A) the antimicrobial potential; (B) the durability, thermotolerance, and bioavailability; (C) cytotoxicity, and another, unwanted side effects, especially if one group of target organisms are of eukaryotic (protist) pathogens.
- We have not found any publication concerning the comparisons of the in vitro and the in vivo effects of antimicrobial active NR-AMP molecules of EPB origin on the same eukaryote (host) organism to be protected from pathogens or parasites.
- Herein we demonstrated that both the heat-inactivated and the native cell-free conditioned culture media (CFCM) of Xenorhabdus budapestensis DSM16342 (EMA), and that of Xenorhabdus szentirmaii DSM16338 (EMC) which has broad-spectrum antimicrobial activity against several prokaryotic and eukaryotic microbial pathogens, also exerted a robust cytopathogenic effect on confluent (cultured) chicken cell layer.
- Whether cytotoxicity and antibiotic potential of the same NR-AMP molecule is an open question.
- The results of the in vivo experiment presented in Table 2, Table 3 and Table 4 may allow concluding that XENOFOOD feeding was harmless. It means that the NR-AMPs, present in the CFCM of X. budapestensis and X. szentirmaii-at least when applied as autoclaved food ingredients-did not cause any detectable side effects in vivo in broilers.
- The incorporation (by covalent chemical bounds, or complex formation) of non-decomposed NR-AMPs into proteins or other tissue components is biochemical nonsense.
- However, their deposition into the egg yolk cannot theoretically be ruled out, therefore, we may recommend XENOFOOD as protecting food supplement only for cockerels but not for pullets.
- The XENOFOOD exerted gastrointestinal antimicrobial activity in the GI has been reflected in the reduced average value of the Clostridium CFUs in the XENOFOOD-fed group.
- We suppose that the bursa-dependent humoral immune system neutralized the cytotoxic side components (of peptide nature) of the XENOFOOD, (that is, cytotoxic NR-AMPs of CFCMs in the blood (but, naturally, not in the gut).
- The presence of the active antimicrobial compounds in the GI is proved by the significantly reduced number of colony-forming germs in the lower jejunum of the XENOFOOD-fed (T-group of) animals compared to that of the controls, (C-group). Based on those facts, we may recommend XENOFOOD as a useful food supplement to protect broiler cockerels against coccidiosis.
- However, before drawing that conclusion, we recommend another experiment on experimentally Clostridium-pre-infested chickens, (also on cockerels, not pullet) to reproducibly determine the in vivo anti-Clostridial effects of the XENOFOOD diet quantitatively. (As mentioned above, we do not recommend the use of pullets, because the deposition of the XENOFOOD ingredients is unpredictable).
Supplementary Materials
Author Contributions
Funding
Institutional Review Board Statement
Informed Consent Statement
Data Availability Statement
Acknowledgments
Conflicts of Interest
References
- Huang, W.; Reyes-Caldas, P.; Mann, M.; Seifbarghi, S.; Kahn, A.; Almeida, R.P.; Béven, L.; Heck, M.; Hogenhout, S.A.; Coaker, G. Bacterial Vector-Borne Plant Diseases: Unanswered Questions and Future Directions. Mol. Plant 2020, 13, 1379–1393. [Google Scholar] [CrossRef] [PubMed]
- Białas, A.; Zess, E.K.; De la Concepcion, J.C.; Franceschetti, M.; Pennington, H.G.; Yoshida, K.; Upson, J.L.; Chanclud, E.; Wu, C.-H.; Langner, T.; et al. Lessons in Effector and NLR Biology of Plant-Microbe Systems. Mol. Plant-Microbe Interact. 2018, 31, 34–45. [Google Scholar] [CrossRef]
- Monzon, F.C.; Rödel, M.-O.; Jeschke, J.M. Tracking Batrachochytrium dendrobatidis Infection Across the Globe. EcoHealth 2020, 17, 270–279. [Google Scholar] [CrossRef]
- Kolářová, I.; Valigurová, A. Hide-and-Seek: A Game Played between Parasitic Protists and Their Hosts. Microorganisms 2021, 9, 2434. [Google Scholar] [CrossRef]
- Itoïz, S.; Metz, S.; Derelle, E.; Reñé, A.; Garcés, E.; Bass, D.; Soudant, P.; Chambouvet, A. Emerging Parasitic Protists: The Case of Perkinsea. Front. Microbiol. 2022, 12, 735815. [Google Scholar] [CrossRef] [PubMed]
- Preston, S.; Jabbar, A.; Gasser, R.B. A perspective on genomic-guided anthelmintic discovery and repurposing using Haemonchus contortus. Infect. Genet. Evol. 2016, 40, 368–373. [Google Scholar] [CrossRef]
- Zuo, Y.; Shi, Y.; Zhang, F.; Guan, F.; Zhang, J.; Feyereisen, R.; Fabrick, J.A.; Yang, Y.; Wu, Y. Genome mapping coupled with CRISPR gene editing reveals a P450 gene confers avermectin resistance in the beet armyworm. PLoS Genet. 2021, 17, e1009680. [Google Scholar] [CrossRef] [PubMed]
- Sokół, R.; Gałęcki, R. The resistance of Eimeria spp. to toltrazuril in black grouse (Lyrurus tetrix) kept in an aviary. Poult. Sci. 2018, 97, 4193–4199. [Google Scholar] [CrossRef]
- Akhter, M.; Aziz, F.; Hasan, M.; Islam, R.; Parvez, M.; Sarkar, S.; Meher, M. Comparative effect of papaya (Carica papaya) leaves’ extract and Toltrazuril on growth performance, hematological parameter, and protozoal load in Sonali chickens infected by mixed Eimeria spp. J. Adv. Veter-Anim. Res. 2021, 8, 91–100. [Google Scholar] [CrossRef]
- Hawkins, N.J.; Fraaije, B.A. Contrasting levels of genetic predictability in the evolution of resistance to major classes of fungicides. Mol. Ecol. 2021, 30, 5318–5327. [Google Scholar] [CrossRef]
- Knutie, S.A.; Wilkinson, C.L.; Kohl, K.D.; Rohr, J.R. Early-life disruption of amphibian microbiota decreases later-life resistance to parasites. Nat. Commun. 2017, 8, 86. [Google Scholar] [CrossRef]
- Uddin, T.M.; Chakraborty, A.J.; Khusro, A.; Zidan, B.R.M.; Mitra, S.; Bin Emran, T.; Dhama, K.; Ripon, K.H.; Gajdács, M.; Sahibzada, M.U.K.; et al. Antibiotic resistance in microbes: History, mechanisms, therapeutic strategies and future prospects. J. Infect. Public Health 2021, 14, 1750–1766. [Google Scholar] [CrossRef] [PubMed]
- Fodor, A.; Abate, B.A.; Deák, P.; Fodor, L.; Gyenge, E.; Klein, M.G.; Koncz, Z.; Muvevi, J.; Ötvös, L.; Székely, G.; et al. Multidrug Resistance (MDR) and Collateral Sensitivity in Bacteria, with Special Attention to Genetic and Evolutionary Aspects and to the Perspectives of Antimicrobial Peptides—A Review. Pathogens 2020, 9, 522. [Google Scholar] [CrossRef]
- Otvos, L.; Wade, J.D. Current challenges in peptide-based drug discovery. Front. Chem. 2014, 2, 62. [Google Scholar] [CrossRef]
- Carton, J.M.; Strohl, W.R. Protein therapeutics (Introduction to biopharmaceuticals). In Biological and Small Molecule Drug Research and Development; Ganelin, R., Jefferts, R., Roberts, S., Eds.; Academic Press: Waltham, MA, USA, 2013; pp. 127–159. [Google Scholar]
- Lázár, V.; Martins, A.; Spohn, R.; Daruka, L.; Grézal, G.; Fekete, G.; Számel, M.; Jangir, P.; Kintses, B.; Csörgő, B.; et al. Antibiotic-resistant bacteria show widespread collateral sensitivity to antimicrobial peptides. Nat. Microbiol. 2018, 3, 718–731. [Google Scholar] [CrossRef]
- Kintses, B.; Jangir, P.K.; Fekete, G.; Számel, M.; Méhi, O.; Spohn, R.; Daruka, L.; Martins, A.; Hosseinnia, A.; Gagarinova, A.; et al. Chemical-genetic profiling reveals limited cross-resistance between antimicrobial peptides with different modes of action. Nat. Commun. 2019, 10, 1–13. [Google Scholar] [CrossRef]
- Mojsoska, B.; Jenssen, H. Peptides and Peptidomimetics for Antimicrobial Drug Design. Pharmaceuticals 2015, 8, 366–415. [Google Scholar] [CrossRef] [PubMed]
- Jenssen, H.; Hamill, P.; Hancock, R.E.W. Peptide Antimicrobial Agents. Clin. Microbiol. Rev. 2006, 19, 491–511. [Google Scholar] [CrossRef]
- Ostorhazi, E.; Hoffmann, R.; Herth, N.; Wade, J.D.; Kraus, C.N.; Otvos, L., Jr. Advantage of a Narrow Spectrum Host Defense (Antimicrobial) Peptide Over a Broad Spectrum Analog in Preclinical Drug Development. Front. Chem. 2018, 6, 359. [Google Scholar] [CrossRef] [PubMed]
- Ostorhazi, E.; Holub, M.C.; Rozgonyi, F.; Harmos, F.; Cassone, M.; Wade, J.D.; Otvos, L., Jr. Broad-spectrum antimicrobial efficacy of peptide A3-APO in mouse models of multidrug-resistant wound and lung infections cannot be explained by in vitro activity against the pathogens involved. Int. J. Antimicrob. Agents 2011, 37, 480–484. [Google Scholar] [CrossRef]
- Ötvös, L., Jr. Immunomodulatory effects of anti-microbial peptides. Acta Microbiol. Immunol. Hung. 2016, 63, 257–277. [Google Scholar] [CrossRef]
- Petkovic, M.; Mouritzen, M.V.; Mojsoska, B.; Jenssen, H. Immunomodulatory Properties of Host Defence Peptides in Skin Wound Healing. Biomolecules 2021, 11, 952. [Google Scholar] [CrossRef]
- Jenssen, H.; Fjell, C.D.; Cherkasov, A.; Hancock, R.E.W. QSAR modeling and computer-aided design of antimicrobial peptides. J. Pept. Sci. 2007, 14, 110–114. [Google Scholar] [CrossRef] [PubMed]
- Mojsoska, B.; Zuckermann, R.N.; Jenssen, H. Structure-Activity Relationship Study of Novel Peptoids That Mimic the Structure of Antimicrobial Peptides. Antimicrob. Agents Chemother. 2015, 59, 4112–4120. [Google Scholar] [CrossRef] [PubMed]
- Tsakou, F.; Jersie-Christensen, R.; Jenssen, H.; Mojsoska, B. The Role of Proteomics in Bacterial Response to Antibiotics. Pharmaceuticals 2020, 13, 214. [Google Scholar] [CrossRef] [PubMed]
- Ötvös, L., Jr. The short proline-rich antibacterial peptide family. Cell Mol. Life Sci. 2002, 59, 1138–1150. [Google Scholar] [CrossRef]
- Chang, K.-P.; Reed, S.G.; McGwire, B.S.; Soong, L. Leishmania model for microbial virulence: The relevance of parasite multiplication and pathoantigenicity. Acta Trop. 2002, 85, 375–390. [Google Scholar] [CrossRef] [PubMed]
- McGwire, B.S.; Kulkarni, M.M. Interactions of antimicrobial peptides with Leishmania and trypanosomes and their functional role in host parasitism. Exp. Parasitol. 2010, 126, 397–405. [Google Scholar] [CrossRef]
- Kulkarni, M.M.; McMaster, W.R.; Kamysz, W.; McGwire, B.S. Antimicrobial Peptide-induced Apoptotic Death of Leishmania Results from Calcium-de pend ent, Caspase-independent Mitochondrial Toxicity. J. Biol. Chem. 2009, 284, 15496–15504. [Google Scholar] [CrossRef]
- Akhurst, R.J. Antibiotic activity of Xenorhabdus spp., bac 190 teria symbiotically associated with insect pathogenic nematodes of the families Heterorhabditidae and Steinernematidae. J. Gen. Microbiol. 1982, 128, 3061. [Google Scholar]
- Ogier, J.-C.; Pagès, S.; Frayssinet, M.; Gaudriault, S. Entomopathogenic nematode-associated microbiota: From monoxenic paradigm to pathobiome. Microbiome 2020, 8, 1–17. [Google Scholar] [CrossRef]
- McGwire, B.S.; Olson, C.L.; Tack, B.F.; Engman, D.M. Killing of African Trypanosomes by Antimicrobial Peptides. J. Infect. Dis. 2003, 188, 146–152. [Google Scholar] [CrossRef]
- Lengyel, K.; Lang, E.; Fodor, A.; Szállás, E.; Schumann, P.; Stackebrandt, E. Description of four novel species of Xenorhabdus, family Enterobacteriaceae: Xenorhabdus budapestensis sp. nov., Xenorhabdus ehlersii sp. nov., Xenorhabdus innexi sp. nov., and Xenorhabdus szentirmaii sp. nov. Syst. Appl. Microbiol. 2005, 28, 115–122. [Google Scholar] [CrossRef] [PubMed]
- Fodor, A.; Gualtieri, M.; Zeller, M.; Tarasco, E.; Klein, M.G.; Fodor, A.M.; Haynes, L.; Lengyel, K.; Forst, S.A.; Furgani, G.M.; et al. Type Strains of Entomopathogenic Nematode-Symbiotic Bacterium Species, Xenorhabdus szentirmaii (EMC) and X. budapestensis (EMA), Are Exceptional Sources of Non-Ribosomal Templated, Large-Target-Spectral, Thermotolerant-Antimicrobial Peptides (by Both), and Iodinin (by EMC). Pathogens 2022, 11, 342. [Google Scholar] [CrossRef] [PubMed]
- Furgani, G.; Böszörményi, E.; Fodor, A.; Forst, S.; Hogan, J.; Katona, Z.; Klein, M.; Stackebrandt, E.; Szentirmai, A.; Sztaricskai, F.; et al. Xenorhabdus antibiotics: A comparative analysis and potential utility for controlling mastitis caused by bacteria. J. Appl. Microbiol. 2008, 104, 745–758. [Google Scholar] [CrossRef]
- Böszörményi, E.; Érsek, T.; Fodor, A.; Földes, L.; Hevesi, M.; Hogan, J.; Katona, Z.; Klein, M.; Kormány, A.; Pekár, S.; et al. Isolation and activity of Xenorhabdus antimicrobial compounds against the plant pathogens Erwinia amylovora and Phytophthora nicotianae. J. Appl. Microbiol. 2009, 107, 746–759. [Google Scholar] [CrossRef] [PubMed]
- Vozik, D.; Bélafi-Bakó, K.; Hevesi, M.; Böszörményi, E.; Fodor, A. Effectiveness of a Peptide-rich Fraction from Xenorhabdus budapestensis Culture against Fire Blight Disease on Apple Blossoms. Not. Bot. Horti Agrobot. Cluj-Napoca 2015, 43, 547–553. [Google Scholar] [CrossRef]
- Fodor, A.; Makrai, L.; Fodor, L.; Venekei, I.; Husvéth, F.; Pál, L.; Molnár, A.; Dublecz, K.; Pintér, C.; Józsa, S.; et al. Anti-Coccidiosis Potential of Autoclaveable Antimicrobial Peptides from Xenorhabdus budapestensis Resistant to Proteolytic (Pepsin, Trypsin) Digestion Based on In vitro Studies. Microbiol. Res. J. Int. 2018, 22, 1–17. [Google Scholar] [CrossRef]
- Fodor, A.; Varga, I.; Hevesi, M.; Máthé-Fodor, A.; Racsko, J.; Hogan, J.A. Novel anti-microbial peptides of Xenorhabdus origin against multidrug resistant plant pathogens. In A Search for Antibacterial Agents; Bobbarala, V., Ed.; IntechOpen: London, UK, 2012; pp. 3–32. [Google Scholar]
- Bode, E.; Heinrich, A.K.; Hirschmann, M.; Abebew, D.; Shi, Y.; Vo, T.D.; Wesche, F.; Shi, Y.; Grün, P.; Simonyi, S.; et al. Promoter Activation in Δ hfq Mutants as an Efficient Tool for Specialized Metabolite Production Enabling Direct Bioactivity Testing. Angew. Chem. Int. Ed. 2019, 58, 18957–18963. [Google Scholar] [CrossRef]
- Böszörményi, E.B.; Barcs, I.; Domján, G.; Bakó, K.B.; Fodor, A.; Makrai, L.; Vozik, D.; Information, R. A Xenorhabdus budapestensis entomopatogén baktérium sejtmentes fermentlevének és tisztítottfehérje-frakciójának antimikrobiális hatása néhány zoonoticus baktériumra. Orvosi Hetil. 2015, 156, 1782–1786. [Google Scholar] [CrossRef]
- Fuchs, S.W.; Sachs, C.C.; Kegler, C.; Nollmann, F.I.; Karas, M.; Bode, H.B. Neutral Loss Fragmentation Pattern Based Screening for Arginine-Rich Natural Products in Xenorhabdus and Photorhabdus. Anal. Chem. 2012, 84, 6948–6955. [Google Scholar] [CrossRef] [PubMed]
- Fuchs, S.W.; Grundmann, F.; Kurz, M.; Kaiser, M.; Bode, H.B. Fabclavines: Bioactive Peptide-Polyketide-Polyamino Hybrids from Xenorhabdus. Chembiochem 2014, 15, 512–516. [Google Scholar] [CrossRef] [PubMed]
- Wenski, S.L.; Kolbert, D.; Grammbitter, G.L.C.; Bode, H.B. Fabclavine biosynthesis in X. szentirmaii: Shortened derivatives and characterization of the thioester reductase FclG and the condensation domain-like protein FclL. J. Ind. Microbiol. Biotechnol. 2019, 46, 565–572. [Google Scholar] [CrossRef] [PubMed]
- Wenski, S.L.; Cimen, H.; Berghaus, N.; Fuchs, S.W.; Hazir, S.; Bode, H.B. Fabclavine diversity in Xenorhabdus bacteria. Beilstein J. Org. Chem. 2020, 16, 956–965. [Google Scholar] [CrossRef]
- Amin, A.; Bilic, I.; Berger, E.; Hess, M. Trichomonas gallinae, in comparison to Tetratrichomonas gallinarum, induces distinctive cytopathogenic effects in tissue cultures. Vet. Parasitol. 2012, 186, 196–206. [Google Scholar] [CrossRef] [PubMed]
- Kawaguchi, T.; Nomura, K.; Hirayama, Y.; Kitagawa, T. Establishment and characterization of a chicken hepatocellular carcinoma cell line, LMH. Cancer Res. 1987, 47, 4460–4464. [Google Scholar]
- Tietze, A.; Shi, Y.; Kronenwerth, M.; Bode, H.B. Nonribosomal Peptides Produced by Minimal and Engineered Synthetases with Terminal Reductase Domains. Chembiochem 2020, 21, 2750–2754. [Google Scholar] [CrossRef]
- Bode, H.B.; Reimer, D.; Fuchs, S.W.; Kirchner, F.; Dauth, C.; Kegler, C.; Lorenzen, D.-P.W.; Brachmann, A.O.; Grün, P. Determination of the Absolute Configuration of Peptide Natural Products by Using Stable Isotope Labeling and Mass Spectrometry. Chem. Eur. J. 2012, 18, 2342–2348. [Google Scholar] [CrossRef]
- Wenski, S.L.; Berghaus, N.; Keller, N.; Bode, H.B. Structure and biosynthesis of deoxy-polyamine in Xenorhabdus bovienii. J. Ind. Microbiol. Biotechnol. 2021, 48, kuab006. [Google Scholar] [CrossRef]
- Xiao, Y.; Meng, F.; Qiu, D.; Yang, X. Two novel antimicrobial peptides purified from the symbiotic bacteria Xenorhabdus budapestensis NMC-10. Peptides 2012, 35, 253–260. [Google Scholar] [CrossRef]
- Xi, X.; Lu, X.; Zhang, X.; Bi, Y.; Li, X.; Yu, Z. Two novel cyclic depsipeptides Xenematides F and G from the entomopathogenic bacterium Xenorhabdus budapestensis. J. Antibiot. 2019, 72, 736–743. [Google Scholar] [CrossRef]
- Brachmann, A.O.; Forst, S.; Furgani, G.M.; Fodor, A.; Bode, H.B. Xenofuranones A and B: Phenylpyruvate Dimers from Xenorhabdus szentirmaii. J. Nat. Prod. 2006, 69, 1830–1832. [Google Scholar] [CrossRef] [PubMed]
- Shi, Y.-M.; Brachmann, A.O.; Westphalen, M.A.; Neubacher, N.; Tobias, N.J.; Bode, H.B. Dual phenazine gene clusters enable diversification during biosynthesis. Nat. Chem. Biol. 2019, 15, 331–339. [Google Scholar] [CrossRef] [PubMed]
- Ohlendorf, B.; Simon, S.; Wiese, J.; Imhoff, J.F. Szentiamide, an N-formylated Cyclic Depsipeptide from Xenorhabdus szentirmaii DSM 16338T. Nat. Prod. Commun. 2011, 6, 1247–1250. [Google Scholar] [CrossRef] [PubMed]
- Nollmann, F.I.; Dowling, A.; Kaiser, M.; Deckmann, K.; Grösch, S.; Ffrench-Constant, R.; Bode, H.B. Synthesis of szentiamide, a depsipeptide from entomopathogenic Xenorhabdus szentirmaii with activity against Plasmodium falciparum. Beilstein J. Org. Chem. 2012, 8, 528–533. [Google Scholar] [CrossRef]
- Gualtieri, M.; Ogier, J.-C.; Pagès, S.; Givaudan, A.; Gaudriault, S. Draft Genome Sequence and Annotation of the Entomopathogenic Bacterium Xenorhabdus szentirmaii Strain DSM16338. Genome Announc. 2014, 2, e00190-14. [Google Scholar] [CrossRef]
- Gualtieri, M.; Banéres-Roquet, F.; Villain-Guillot, P.; Pugnière, M.; Leonetti, J.-P. The antibiotics in the chemical space. Curr. Med. Chem. 2009, 16, 390–393. [Google Scholar] [CrossRef]
- Gualtieri, M.; Villain-Guillot, P.; Givaudan, A.; Pages, S. Nemaucin, an Antibiotic Produced by Entomopathogenic Xenorhabdus cabanillasii. France Patent WO2012085177A1, 28 June 2012. [Google Scholar]
- Houard, J.; Aumelas, A.; Noël, T.; Pages, S.; Givaudan, A.; Fitton-Ouhabi, V.; Villain-Guillot, P.; Gualtieri, M. Cabanillasin, a new antifungal metabolite, produced by entomopathogenic Xenorhabdus cabanillasii JM26. J. Antibiot. 2013, 66, 617–620. [Google Scholar] [CrossRef]
- Gualtieri, M.; Aumelas, A.; Thaler, J.-O. Identification of a new antimicrobial lysine-rich cyclolipopeptide family from Xenorhabdus nematophila. J. Antibiot. 2009, 62, 295–302. [Google Scholar] [CrossRef]
- Fuchs, S.W.; Proschak, A.; Jaskolla, T.W.; Karas, M.; Bode, H.B. Structure elucidation and biosynthesis of lysine-rich cyclic peptides in Xenorhabdus nematophila. Org. Biomol. Chem. 2011, 9, 3130–3132. [Google Scholar] [CrossRef]
- Dreyer, J.; Rautenbach, M.; Booysen, E.; Van Staden, A.D.; Deane, S.M.; Dicks, L.M.T. Xenorhabdus khoisanae SB10 produces Lys-rich PAX lipopeptides and a Xenocoumacin in its antimicrobial complex. BMC Microbiol. 2019, 19, 132. [Google Scholar] [CrossRef]
- Isaacson, P.; Webster, J. Antimicrobial activity of Xenorhabdus sp. RIO (Enterobacteriaceae), symbiont of the entomopathogenic nematode, Steinernema riobrave (Rhabditida: Steinernematidae). J. Invertebr. Pathol. 2002, 79, 146–153. [Google Scholar] [CrossRef]
- Pantel, L.; Florin, T.; Dobosz-Bartoszek, M.; Racine, E.; Sarciaux, M.; Serri, M.; Houard, J.; Campagne, J.-M.; de Figueiredo, R.M.; Midrier, C.; et al. Odilorhabdins, Antibacterial Agents that Cause Miscoding by Binding at a New Ribosomal Site. Mol. Cell 2018, 70, 83–94.e7. [Google Scholar] [CrossRef] [PubMed]
- Sarciaux, M.; Pantel, L.; Midrier, C.; Serri, M.; Gerber, C.; de Figueiredo, R.M.; Campagne, J.-M.; Villain-Guillot, P.; Gualtieri, M.; Racine, E. Total Synthesis and Structure–Activity Relationships Study of Odilorhabdins, a New Class of Peptides Showing Potent Antibacterial Activity. J. Med. Chem. 2018, 61, 7814–7826. [Google Scholar] [CrossRef] [PubMed]
- Racine, E.; Gualtieri, M. From Worms to Drug Candidate: The Story of Odilorhabdins, a New Class of Antimicrobial Agents. Front. Microbiol. 2019, 10, 2893. [Google Scholar] [CrossRef] [PubMed]
- Lanois-Nouri, A.; Pantel, L.; Fu, J.; Houard, J.; Ogier, J.-C.; Polikanov, Y.S.; Racine, E.; Wang, H.; Gaudriault, S.; Givaudan, A.; et al. The Odilorhabdin Antibiotic Biosynthetic Cluster and Acetyltransferase Self-Resistance Locus Are Niche and Species Specific. Mbio 2022, 13, e0282621. [Google Scholar] [CrossRef] [PubMed]
- Reimer, D.; Nollmann, F.I.; Schultz, K.; Kaiser, M.; Bode, H.B. Xenortide Biosynthesis by Entomopathogenic Xenorhabdus nematophila. J. Nat. Prod. 2014, 77, 1976–1980. [Google Scholar] [CrossRef]
- Esmati, N.; Maddirala, A.R.; Hussein, N.; Amawi, H.; Tiwari, A.K.; Andreana, P.R. Efficient syntheses and anti-cancer activity of xenortides A–D including ent/epi-stereoisomers. Org. Biomol. Chem. 2018, 16, 5332–5342. [Google Scholar] [CrossRef] [PubMed]
- Reimer, D.; Cowles, K.N.; Proschak, A.; Nollmann, F.I.; Dowling, A.J.; Kaiser, M.; Constant, R.F.; Goodrich-Blair, H.; Bode, H.B. Rhabdopeptides as Insect-Specific Virulence Factors from Entomopathogenic Bacteria. ChemBioChem 2013, 14, 1991–1997. [Google Scholar] [CrossRef]
- Bi, Y.; Gao, C.; Yu, Z. Rhabdopeptides from Xenorhabdus budapestensis SN84 and Their Nematicidal Activities against Meloidogyne incognita. J. Agric. Food Chem. 2018, 66, 3833–3839. [Google Scholar] [CrossRef]
- Zhao, L.; Kaiser, M.; Bode, H.B. Rhabdopeptide/Xenortide-like Peptides from Xenorhabdus innexi with Terminal Amines Showing Potent Antiprotozoal Activity. Org. Lett. 2018, 20, 5116–5120. [Google Scholar] [CrossRef] [PubMed]
- Duchaud, E.; Rusniok, C.; Frangeul, L.; Buchrieser, C.; Givaudan, A.; Taourit, S.; Bocs, S.; Boursaux-Eude, C.; Chandler, M.; Charles, J.-F.; et al. The genome sequence of the entomopathogenic bacterium Photorhabdus luminescens. Nat. Biotechnol. 2003, 21, 1307–1313. [Google Scholar] [CrossRef] [PubMed]

| Samples | Replicates | 24 h | 48 h |
|---|---|---|---|
| M199 the original (unchanged) culture Media, in which LMH layer had been developed | A | 0 | 0 |
| B | 0 | 0 | |
| C | 0 | 0 | |
| Fresh (199 + 15% + PKS) culture media added | A | 0 | 0 |
| A | |||
| B | 0 | 0 | |
| C | 0 | 0 | |
| EMA CFCM (EMA had been cultured inM199) | A | 3 | 4 |
| B | 3 | 4 | |
| C | 3 | 4 | |
| EMC CFCM (EMC had been cultured inM199) | A | 4 | 4 |
| B | 4 | 4 | |
| C | 4 | 4 | |
| TT01 YELLOW CFCM (TT01 had been cultured inM199) | A | 4 | 4 |
| B | 4 | 4 | |
| C | 4 | 4 | |
| TT01 RED CFCM TT01 had been cultured inM199) | A | 4 | 4 |
| B | 4 | 4 | |
| C | 4 | 4 |
| TREATMENTS | N | No. of Clostridium CFU in the Lower Ileum |
|---|---|---|
| C (Control) | 10 | 149.9 |
| T (Xenofood-fed) | 10 | 48.1 |
| t | −2.128733 | |
| p | 0.028 | |
| Significance |
| Treatments | Spleen | Bursa of Fabricius | |||
|---|---|---|---|---|---|
| Weight | Weight | Size | Individual Bursa/Spleen | ||
| N | mg | mg | mm | Ratio | |
| C (Control) | 10 | 2266.6 | 2761.0 | 25.2 | 1.39 |
| T (Xenofood-fed) | 10 | 1618.0 | 3618.2 | 26.9 | 2.38 |
| t | +2.09 | +3.16 | 3.02 | 3.7 | |
| p | 0.056 | 0.006 | 0.009 | 0.006 | |
| Significance | NS | ||||
| Treatments | Growing Periods (Days) | ||
|---|---|---|---|
| Starter (1–10) | Grower (11–24) | Finisher (25–42) | |
| Feed intake | |||
| C (Control) | 256 ± 14.9 | 1401 ± 43.8 | 3267 ± 113.3 |
| T (XENOFOOD-fed) | 267 ± 14.3 | 1435 ± 39.5 | 3376 ± 74.4 |
| Significance | ns | ns | ns |
| Weight gain | |||
| C (Control) | 202.7 ± 12.5 | 950.4 ± 22.9 | 1486 ± 158.9 |
| T (XENOFOOD-fed) | 213.2 ± 10.7 | 975.6 ± 64.5 | 1600 ± 63.7 |
| Significance | ns | ns | ns |
| FCR | |||
| C (Control) | 1.05 ± 0.04 | 1.48 ± 0.03 | 2.42 ± 0.40 |
| T (XENOFOOD-fed) | 1.05 ± 0.02 | 1.47 ± 0.08 | 2.26 ± 0.13 |
| Significance | ns | ns | ns |
| Natural NR-AMPs | Xenorhabus Species | Reference |
|---|---|---|
| Xenofuranone A and B | X. szetirmaii (EMC) DSM(16338)T | Brachmann, et al., 2006 [54] |
| Nemaucin | X. cabanillasii | Gualtieri, et al., 2009a [59], Gualtieri, et al., 2012 [60] |
| Fabclavine | X. budapestensis DSM16342)T (EMA) | Fuchs et al., 2012 [43] |
| Fabclavine, A, B | X. szentirmaii DSM(16338)T (EMC) | Fuchs et al., 2014 [44] |
| Fabclavine, biosynthetic intermediaries, derivatives, and analogs | X. szentirmaii DSM(16338)T (EMC) All but e few Xenorhabdus | Wenski et al., 2019 [45] Wenski et al., 2020 [46] |
| Cabanillasin | X. cabanillasii, X. khoisanae, SB10 | Houard et al., 2013 [61] |
| PAX peptides | X. nematophila | Gualtieri et al., 2009b [62] |
| Fuchs et al., 2011 [63] | ||
| X. khoisanae, SB10 | Dreyer, et al., 2019 [64] | |
| Odilorhabdins | X. riobrave | Isaacson and Webster, 2013 [65] |
| Pantel, et al., 2018 [66] | ||
| Sarciaux et al., 2018 [67] | ||
| Racine, and Gualtieri 2019 [68] | ||
| Lanois-Nouri, et al., 2022 [69] | ||
| Anti-oomycete peptides | X. budapestensis NMC-10 | Xiao et al., 2012 [52] |
| Xenortide | X. nematophila | Reimer, 2014 [70] |
| Xenortide A-D | X. nematophila | Esmati, et al., 2018 [71] |
| Rhabdopeptide | X. nematophila | Reimer, et al., 2013 [72] |
| Rhabdopeptide (with nematicide activity) | X. budapestensis SN84 | Bi et al., 2018 [73] |
| Rhabdoopeptide/xenortide-like peptides | Xenorhabdus innexi | Zhao, 2018 [53] |
| New cyclic depsipeptide xenematide F, and G, (anti-oomycete activity) | X. budapestensis SN84 | Xi et al., 2019 [74] |
| Szentiamide | X. szentirmaii DSM16338T (EMC) | Ohlendorf, et al., 2011 [56] |
| Nollmann, et al., 2012 [57] | ||
| Genomic information: 71 NR-AMP operons in. | X. szetirmaii (EMC)T DSM16338 | Gualtieri et al., 2014 [58] |
Disclaimer/Publisher’s Note: The statements, opinions and data contained in all publications are solely those of the individual author(s) and contributor(s) and not of MDPI and/or the editor(s). MDPI and/or the editor(s) disclaim responsibility for any injury to people or property resulting from any ideas, methods, instructions or products referred to in the content. |
© 2023 by the authors. Licensee MDPI, Basel, Switzerland. This article is an open access article distributed under the terms and conditions of the Creative Commons Attribution (CC BY) license (https://creativecommons.org/licenses/by/4.0/).
Share and Cite
Fodor, A.; Vellai, T.; Hess, C.; Makrai, L.; Dublecz, K.; Pál, L.; Molnár, A.; Klein, M.G.; Tarasco, E.; Józsa, S.; et al. XENOFOOD—An Autoclaved Feed Supplement Containing Autoclavable Antimicrobial Peptides—Exerts Anticoccidial GI Activity, and Causes Bursa Enlargement, but Has No Detectable Harmful Effects in Broiler Cockerels despite In Vitro Detectable Cytotoxicity on LHM Cells. Pathogens 2023, 12, 458. https://doi.org/10.3390/pathogens12030458
Fodor A, Vellai T, Hess C, Makrai L, Dublecz K, Pál L, Molnár A, Klein MG, Tarasco E, Józsa S, et al. XENOFOOD—An Autoclaved Feed Supplement Containing Autoclavable Antimicrobial Peptides—Exerts Anticoccidial GI Activity, and Causes Bursa Enlargement, but Has No Detectable Harmful Effects in Broiler Cockerels despite In Vitro Detectable Cytotoxicity on LHM Cells. Pathogens. 2023; 12(3):458. https://doi.org/10.3390/pathogens12030458
Chicago/Turabian StyleFodor, András, Tibor Vellai, Claudia Hess, László Makrai, Károly Dublecz, László Pál, Andor Molnár, Michael G. Klein, Eustachio Tarasco, Sándor Józsa, and et al. 2023. "XENOFOOD—An Autoclaved Feed Supplement Containing Autoclavable Antimicrobial Peptides—Exerts Anticoccidial GI Activity, and Causes Bursa Enlargement, but Has No Detectable Harmful Effects in Broiler Cockerels despite In Vitro Detectable Cytotoxicity on LHM Cells" Pathogens 12, no. 3: 458. https://doi.org/10.3390/pathogens12030458
APA StyleFodor, A., Vellai, T., Hess, C., Makrai, L., Dublecz, K., Pál, L., Molnár, A., Klein, M. G., Tarasco, E., Józsa, S., Ganas, P., & Hess, M. (2023). XENOFOOD—An Autoclaved Feed Supplement Containing Autoclavable Antimicrobial Peptides—Exerts Anticoccidial GI Activity, and Causes Bursa Enlargement, but Has No Detectable Harmful Effects in Broiler Cockerels despite In Vitro Detectable Cytotoxicity on LHM Cells. Pathogens, 12(3), 458. https://doi.org/10.3390/pathogens12030458

